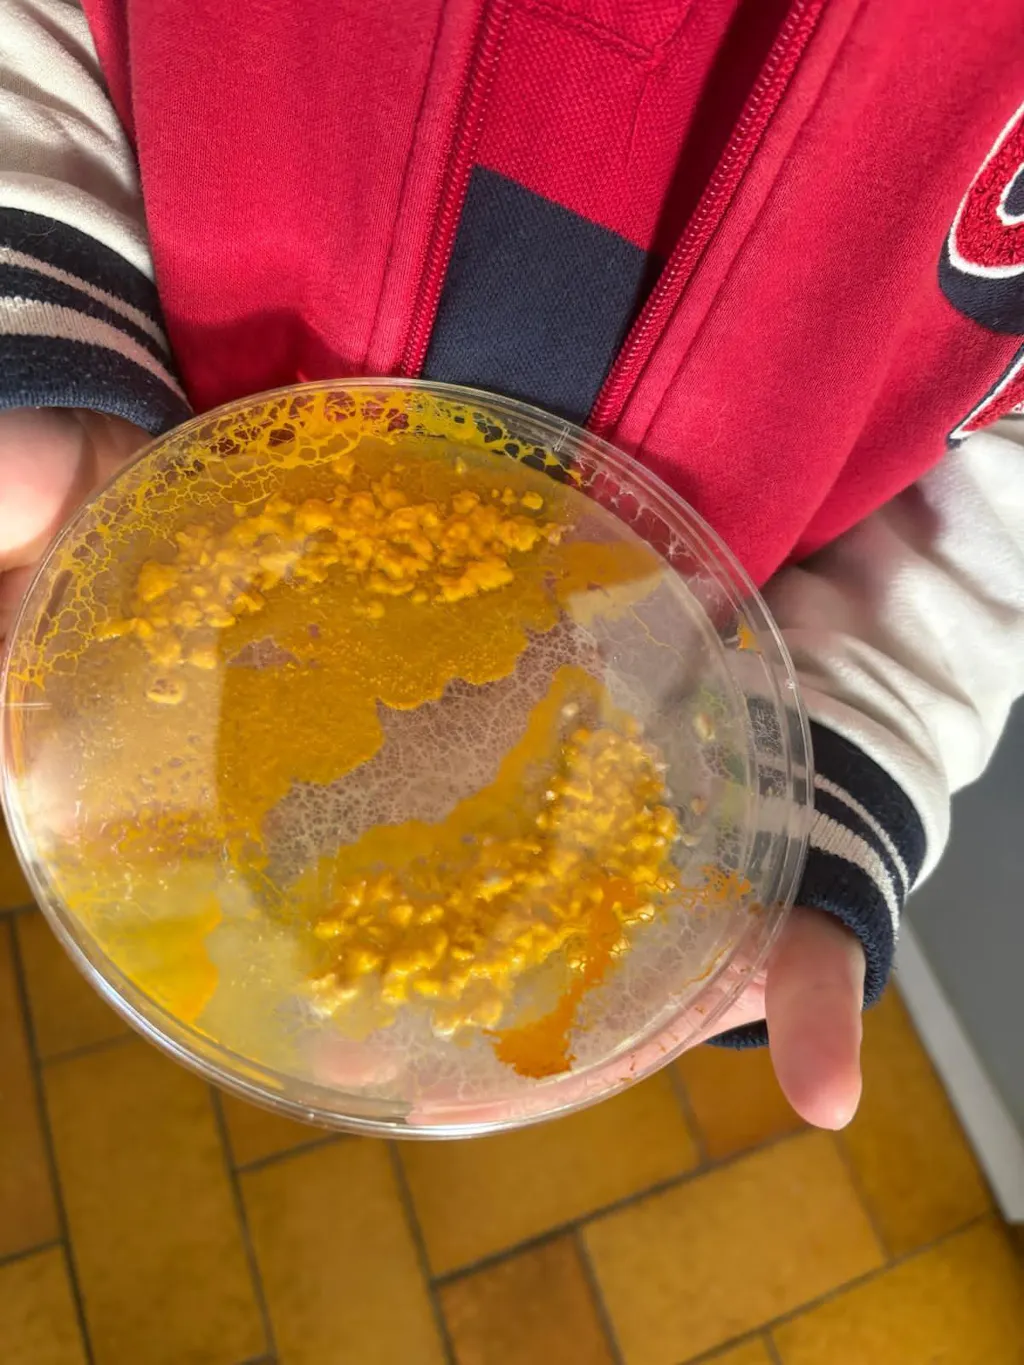

Sclérotes de blob BADHAMIA
🧫 Élevez et étudiez un organisme unique
🧪 Une expérience éducative et ludique
👨👩👦👦 Pour les petits et les grands.
🛏️ Quand le réveiller ? C’est vous qui décidez !

Sclérotes de blob BADHAMIA
Pour ceux qui connaissent bien le blob, et ont déjà tout le matériel nécessaire, nous proposons l'envoi de nouveaux sclérotes pour renouveler l'expérience !
- Deux sclérotes de blob BADHAMIA
Livraison en France
Chez Mister Blob, nous nous efforçons de garantir des livraisons rapides et fiables à nos clients. Pour les livraisons en France métropolitaine, le délai de livraison est estimé entre 48 et 72 heures. Vous pouvez ainsi profiter rapidement de votre achat en toute tranquillité.
Les livraisons sont assurées par La Poste et Colissimo.
Livraison en Europe
Pour nos clients résidant en Europe, le délai de livraison est généralement de 4 jours. Nous travaillons avec des transporteurs de confiance pour assurer que votre colis arrive dans les meilleures conditions et dans les plus brefs délais.
Politique de Retours
Nous comprenons que vous puissiez changer d'avis ou rencontrer des problèmes avec votre commande. C'est pourquoi nous offrons une période de 30 jours après l'achat pour retourner votre colis.
Si le Blob que vous avez reçu ne se réveille pas, nous nous engageons à vous en envoyer un nouveau sans frais supplémentaires.
Pour plus d'Informations
Pour plus d'informations sur notre politique de livraison et de retours, n'hésitez pas à nous contacter sur notre site internet par chat, téléphone ou email.
Comment ça marche ?





Comment ça marche ?
Votre colis sera préparé par notre équipe et vous sera livré dans un délai de 48 à 72 heures.
Découvrez l'intérieur de notre kit : les ustensiles, le blob, les flocons d'avoine, ainsi que notre guide.
Faites à présent chauffer de l'eau et l'agar-agar fournis dans notre coffret, puis disposez votre blob au milieu de la boîte de pétri sur la gélose avec quelques flocons d'avoine et un peu d'eau.
C'est fini ! Laissez à présent votre blob se réveiller. Cela prend en général quelques heures. Vous pourrez le regarder se déplacer pour aller chercher de quoi se nourrir.
Nous vous conseillons de prendre des photos pour comparer l'avant et l'après.
Une fois que votre blob a atteint une bonne forme, vous pouvez commencer à mettre en place des expériences.
Vous verrez qu'il peut être très surprenant !
On répond à vos questions 👩🔬
Explication des différentes souches
▶️ La souche Badhamia : De couleur orangée, ce blob va se réveiller en quelques heures seulement ! Ses déplacements se font en auréoles, sa croissance est spectaculaire, et il ne mettra que 2 ou 3 jours pour coloniser entièrement sa boîte de Petri.
Il est moins exigeant sur les températures, et se développe aussi bien à 17 qu’à 23°C. C’est donc la souche que l’on conseille au débutant, mais aussi à ceux qui ont des maisons fraîches !
Le plus ? C’est une souche qui est naturellement présente en France !
▶️ La souche américaine : se réveille en environ 24h. Sa particularité ? Sa rapidité en déplacement : En une journée, le blob américain peut faire plusieurs fois le tour de la boîte.
Sa technique ? De longs pseudopodes fins, rapides et arborés !
▶️ Le blob australien : lui va avoir tendance à se déplacer dans toutes les directions à la fois, pour optimiser sa recherche. Il est un peu plus lent que ses cousins, mais est réputé pour être le plus « intelligent ».
Lorsqu’on observe le blob australien en timelaps (vidéo accélérée), on pourrait comparer ses déplacements à un feu d’artifice !
▶️ La souche MALU : est un croisement de blob réalisé en laboratoire, avec des origines américaines. Sa particularité ? Avec des déplacements très rapides et un appétit d’ogre, il va aller jusqu’à tripler de taille chaque jour !
C’est La souche que l’on conseille pour les débutants ou encore l’observation en milieu scolaire. Au cours d’une seule journée, son évolution est déjà spectaculaire !
Qu'est-ce qu'un blob ?
Le blob existe depuis des milliards d'années. C'est un organisme étudié en laboratoire qui a encore de nombreux secrets à nous révéler. Immortalité, régénération, mémoire, perception de l'environnement... bien que primitif, il a de quoi intéresser la recherche !
À quoi sert un blob ?
Les blobs sont utilisés dans des études scientifiques pour explorer des domaines tels que la biologie cellulaire, la physiologie ou la recherche médicale.
Est-ce que le blob est un animal ou une plante ?
Ni l'un ni l'autre. Le blob est classé comme un organisme unicellulaire sans catégorisation spécifique comme animal ou plante.
Est-il nécessaire de changer la gélose tous les 3 jours ?
Oui, le changement régulier de la gélose maintient un environnement sain pour la croissance et la survie des blobs.
Que mange le blob ?
Ici on vous fournit le repas valeur sûre (flocons d'avoine), mais à vous de tester une multitude d'aliments pour observer ses préférences !
A quelle vitesse se déplace le blob ?
Le blob se déplace via des pseudopodes, atteignant une vitesse de 4 cm par heure lorsqu'il recherche activement de la nourriture.
Comment cloner un blob ?
Le clonage du blob peut être réalisé en divisant sa masse en sections plus petites, chacune capable de se développer en un nouvel individu.
Quelle odeur a le blob ?
Le blob ne possède pas nécessairement une odeur distinctive. En conditions normales, il n'a pas d'odeur spécifique, mais des changements environnementaux ou des conditions de culture particulières peuvent générer des odeurs spécifiques, bien que légères.